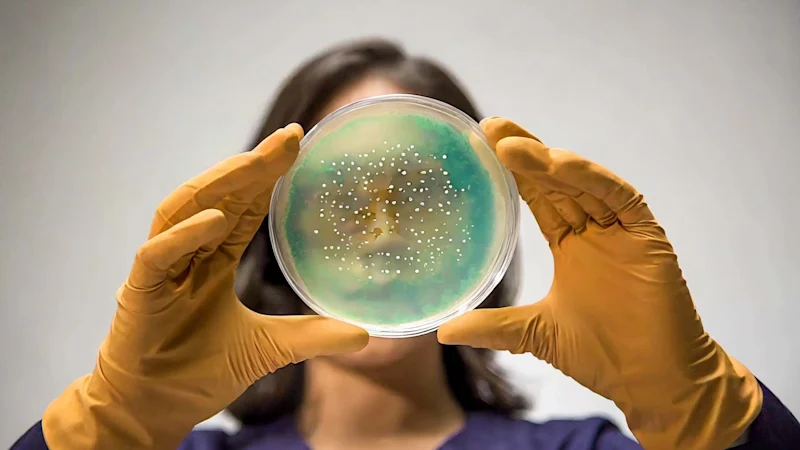
Woman holding up a petri dish and examining it

EU Bioeconomy Strategy Aims to Scale Bio-Based Innovation and Tackle Regulatory Gaps
The EU's new bioeconomy strategy targets regulatory barriers and investment gaps, setting the stage for a competitive, sustainable chemicals ecosystem.

The European Chemicals Agency (ECHA) has recently announced the award of a significant contract focused on enhancing the safety and regulation of industrial chemicals. This initiative represents a pivotal step in the evolution of chemical safety protocols within the European Union.
The primary objective of this tender is to establish two separate Framework Contracts (FWCs) for scientific consulting services. These services are crucial for the development of NAM-based tools and data, specifically tailored for the hazard identification and characterization of industrial chemicals, including complex compounds like polymers and nanoforms.
"Omics" data generation refers to a comprehensive approach in biological research that focuses on the collective characterization and quantification of pools of biological molecules. These molecules can be genes, transcripts, proteins, metabolites, or other types of biological compounds. The term "omics" encompasses various disciplines, each specific to a type of molecule:
In the context of hazard identification and characterization of industrial chemicals, including polymers and nanoforms, "omics" data generation plays a pivotal role:
The use of "omics" technologies allows for a holistic view of the biological impact of chemicals. By analysing the entire spectrum of genes, proteins, and metabolites affected by a chemical, researchers can gain a comprehensive understanding of its potential hazards. This approach is particularly valuable in the study of complex substances like polymers and nanoforms, whose interactions with biological systems may be intricate and multifaceted.
This initiative by the ECHA is a clear indicator of the EU’s commitment to enhancing chemical safety through innovative methodologies. It opens up new possibilities for safer chemical management and sets a precedent for future advancements in this critical field. Stakeholders are advised to closely monitor these developments and proactively integrate them into their safety and regulatory strategies.
Foresight continuously tracks 1000s of sources and maps updates to your portfolio:




The EU's new bioeconomy strategy targets regulatory barriers and investment gaps, setting the stage for a competitive, sustainable chemicals ecosystem.

Companies must report microplastics emissions to ECHA by May 2026 under the EU microplastics restriction. Learn who is affected and how to comply.

ECHA adds DBBPE to the Candidate List of substances of very high concern, triggering new legal obligations for suppliers and importers.
Subscribe to Foresight Weekly and get the latest insights on regulatory changes affecting chemical compliance.
Free forever. Unsubscribe anytime.
Read by professionals at